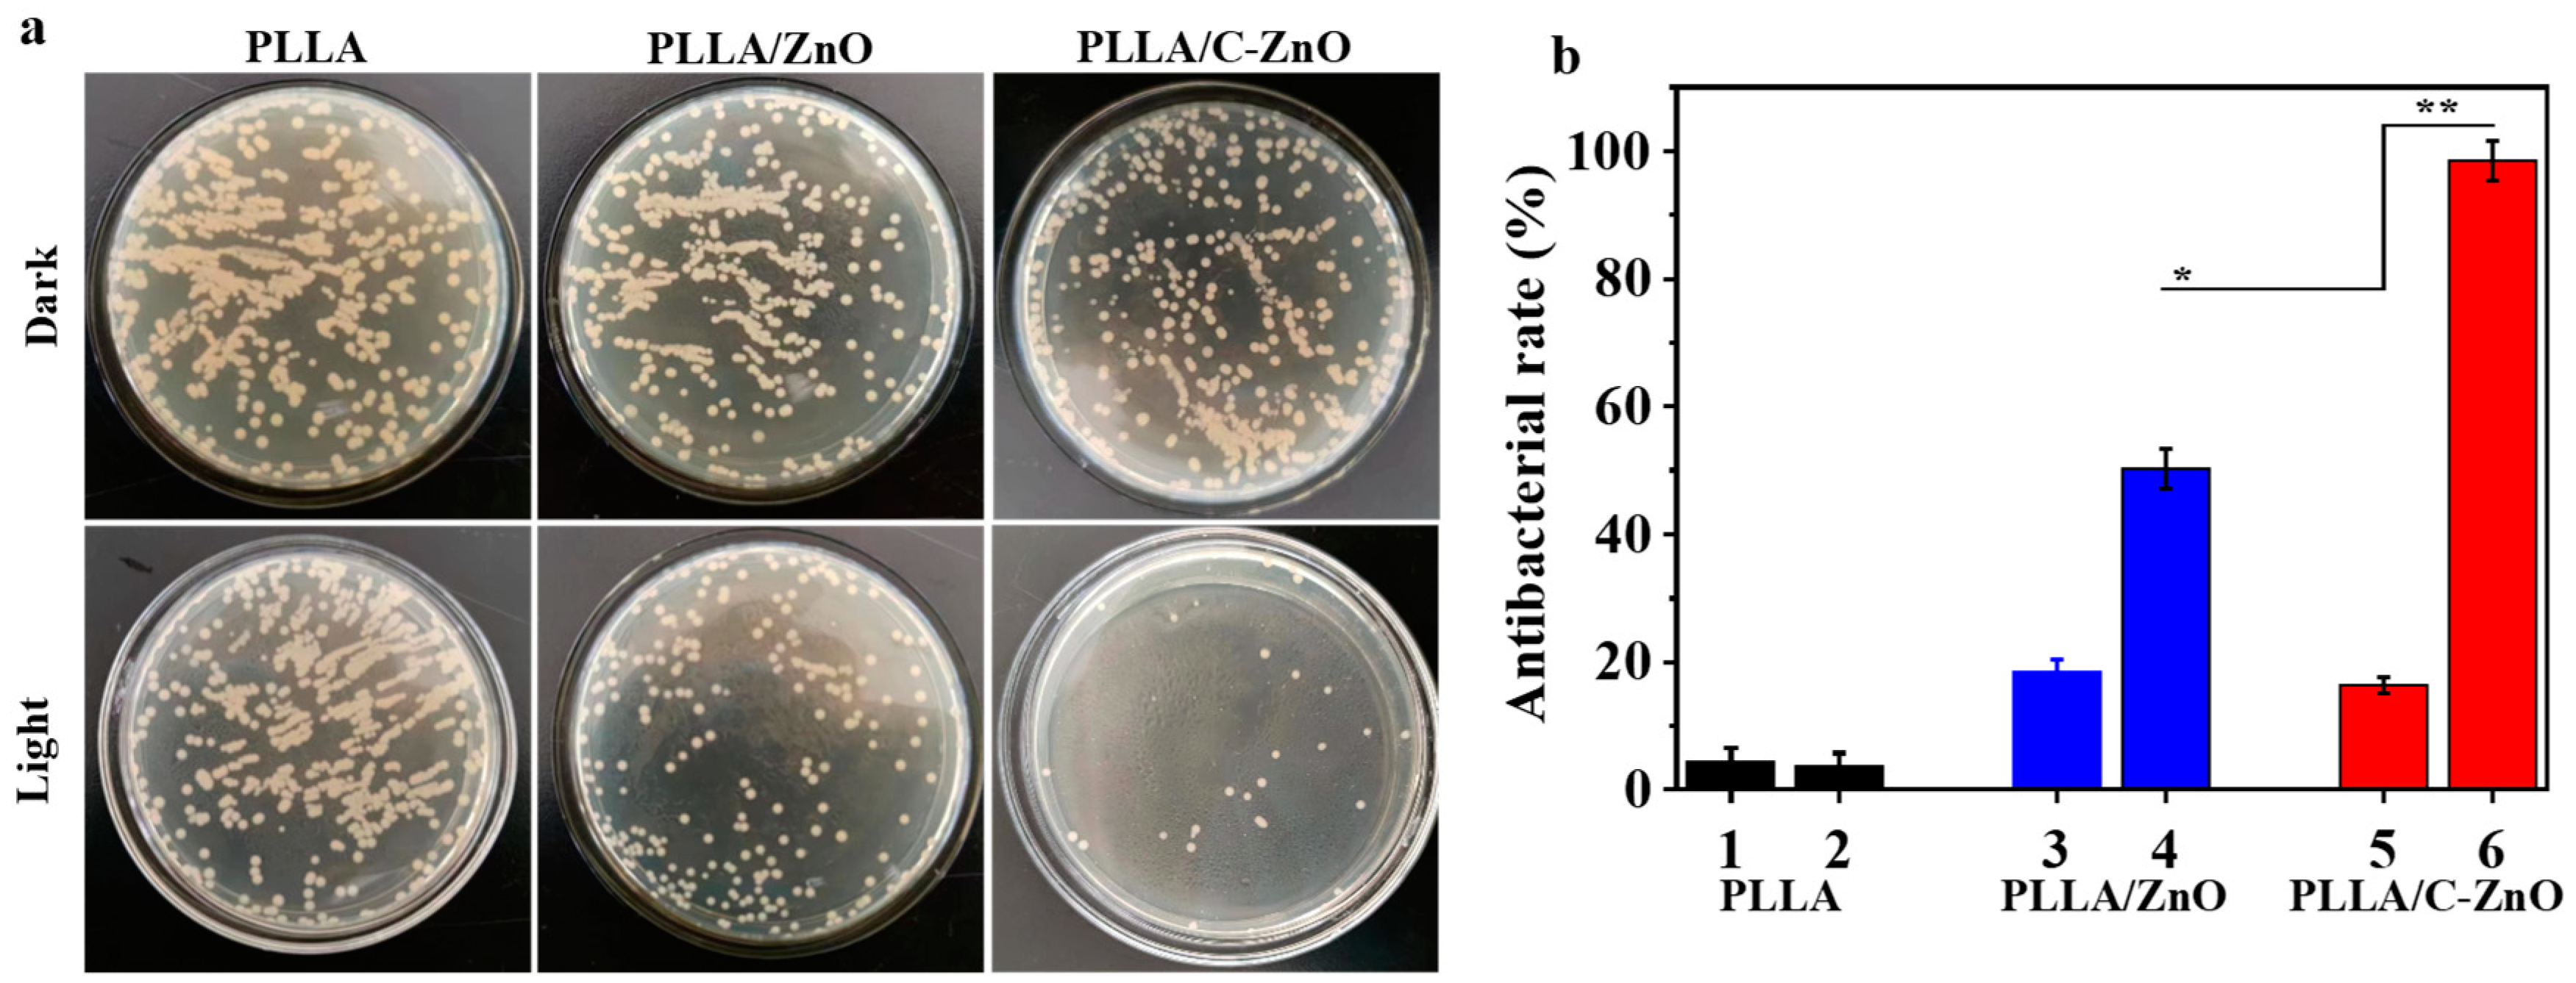
Bioengineering 10 00307 g007 Bioengineering 10 00307 g007

Three-Dimensional Printing of Poly-L-Lactic Acid Composite Scaffolds with Enhanced Bioactivity and Controllable Zn Ion Release Capability by Coupling with Carbon-ZnO
Abstract
1. Introduction
2. Materials and Methods
2.1. Materials
2.2. C–ZnO Preparation
2.3. Scaffold Fabrication
2.4. Analysis and Characterization
2.5. Biodegradability and Zn Ion Release Behavior
2.6. Cell Culture and Bioactivity Characterizations
2.7. Antibacterial Ability
Statistical Analysis
3. Results and Discussion
3.1. Morphology and Structure of C–ZnO
3.2. Biodegradability and Zn Ion Release Behavior
3.3. Cellular Behaviors
4. Conclusions
Author Contributions
Funding
Institutional Review Board Statement
Informed Consent Statement
Data Availability Statement
Acknowledgments
Conflicts of Interest
References
- Zhou, G.; Wang, F.; Lin, G.; Tang, B.; Li, X.; Ding, X.; Wang, W.; Zhang, J.; Shi, Y. Novel coatings for the continuous repair of human bone defects. Colloids Surf. B Biointerfaces 2023, 222, 113127. [Google Scholar] [CrossRef] [PubMed]
- Alonzo, M.; Primo, F.A.; Kumar, S.A.; Mudloff, J.A.; Dominguez, E.; Fregoso, G.; Ortiz, N.; Weiss, W.M.; Joddar, B. Bone tissue engineering techniques, advances, and scaffolds for treatment of bone defects. Curr. Opin. Biomed. Eng. 2021, 17, 100248. [Google Scholar] [CrossRef] [PubMed]
- Bose, S.; Sarkar, N.; Banerjee, D. Natural medicine delivery from biomedical devices to treat bone disorders: A review. Acta Biomater. 2021, 126, 63–91. [Google Scholar] [CrossRef] [PubMed]
- Ho-Shui-Ling, A.; Bolander, J.; Rustom, L.E.; Johnson, A.W.; Luyten, F.P.; Picart, C. Bone regeneration strategies: Engineered scaffolds, bioactive molecules and stem cells current stage and future perspectives. Biomaterials 2018, 180, 143–162. [Google Scholar] [CrossRef]
- Patel, B.B.; Sharifi, F.; Stroud, D.P.; Montazami, R.; Hashemi, N.N.; Sakaguchi, D.S. 3D microfibrous scaffolds selectively promotes proliferation and glial differentiation of adult neural stem cells: A platform to tune cellular behavior in neural tissue engineering. Macromol. Biosci. 2019, 19, 1800236. [Google Scholar] [CrossRef] [PubMed]
- Seidi, A.; Ramalingam, M.; Elloumi-Hannachi, I.; Ostrovidov, S.; Khademhosseini, A. Gradient biomaterials for soft-to-hard interface tissue engineering. Acta Biomater. 2011, 7, 1441–1451. [Google Scholar] [CrossRef]
- Woo, K.M.; Chen, V.J.; Ma, P.X. Nano-fibrous scaffolding architecture selectively enhances protein adsorption contributing to cell attachment. J. Biomed. Mater. Res. 2003, 67, 531–537. [Google Scholar] [CrossRef]
- Dubinenko, G.; Zinoviev, A.; Bolbasov, E.; Kozelskaya, A.; Shesterikov, E.; Novikov, V.; Tverdokhlebov, S. Highly filled poly (l-lactic acid)/hydroxyapatite composite for 3D printing of personalized bone tissue engineering scaffolds. J. Appl. Polym. Sci. 2021, 138, 49662. [Google Scholar] [CrossRef]
- Meng, J.; Boschetto, F.; Yagi, S.; Marin, E.; Adachi, T.; Chen, X.; Pezzotti, G.; Sakurai, S.; Yamane, H.; Xu, H. Design and manufacturing of 3D high-precision micro-fibrous poly (l-lactic acid) scaffold using melt electrowriting technique for bone tissue engineering. Mater. Des. 2021, 210, 110063. [Google Scholar] [CrossRef]
- Dinarvand, P.; Seyedjafari, E.; Shafiee, A.; Jandaghi, A.B.; Doostmohammadi, A.; Fathi, M.H.; Farhadian, S.; Soleimani, M. New Approach to Bone Tissue Engineering: Simultaneous Application of Hydroxyapatite and Bioactive Glass Coated on a Poly(l-lactic acid) Scaffold. ACS Appl. Mater. Interfaces 2011, 3, 4518–4524. [Google Scholar] [CrossRef]
- Liu, S.; Qin, S.; He, M.; Zhou, D.; Qin, Q.; Wang, H. Current applications of poly(lactic acid) composites in tissue engineering and drug delivery. Compos. Part B Eng. 2020, 199, 108238. [Google Scholar] [CrossRef]
- Tyler, B.; Gullotti, D.; Mangraviti, A.; Utsuki, T.; Brem, H. Polylactic acid (PLA) controlled delivery carriers for biomedical applications. Adv. Drug Deliv. Rev. 2016, 107, 163–175. [Google Scholar] [CrossRef] [PubMed]
- O’Connor, J.P.; Kanjilal, D.; Teitelbaum, M.; Lin, S.S.; Cottrell, J.A. Zinc as a Therapeutic Agent in Bone Regeneration. Materials 2020, 13, 2211. [Google Scholar] [CrossRef] [PubMed]
- Hoppe, A.; Güldal, N.S.; Boccaccini, A.R. A review of the biological response to ionic dissolution products from bioactive glasses and glass-ceramics. Biomaterials 2011, 32, 2757–2774. [Google Scholar] [CrossRef] [PubMed]
- Shi, Z.-Z.; Gao, X.-X.; Zhang, H.-J.; Liu, X.-F.; Li, H.-Y.; Zhou, C.; Yin, Y.-X.; Wang, L.-N. Design biodegradable Zn alloys: Second phases and their significant influences on alloy properties. Bioact. Mater. 2020, 5, 210–218. [Google Scholar] [CrossRef]
- Kabir, H.; Munir, K.; Wen, C.; Li, Y. Recent research and progress of biodegradable zinc alloys and composites for biomedical applications: Biomechanical and biocorrosion perspectives. Bioact. Mater. 2020, 6, 836–879. [Google Scholar] [CrossRef]
- Qin, Y.; Liu, A.; Guo, H.; Shen, Y.; Wen, P.; Lin, H.; Xia, D.; Voshage, M.; Tian, Y.; Zheng, Y. Additive manufacturing of Zn-Mg alloy porous scaffolds with enhanced osseointegration: In vitro and in vivo studies. Acta Biomater. 2022, 145, 403–415. [Google Scholar] [CrossRef]
- Zhong, Z.; Wu, X.; Wang, Y.; Li, M.; Li, Y.; Liu, X.; Zhang, X.; Lan, Z.; Wang, J.; Du, Y.; et al. Zn/Sr dual ions-collagen co-assembly hydroxyapatite enhances bone regeneration through procedural osteo-immunomodulation and osteogenesis. Bioact. Mater. 2022, 10, 195–206. [Google Scholar] [CrossRef]
- Hernández-Escobar, D.; Champagne, S.; Yilmazer, H.; Dikici, B.; Boehlert, C.J.; Hermawan, H. Current status and perspectives of zinc-based absorbable alloys for biomedical applications. Acta Biomater. 2019, 97, 1–22. [Google Scholar] [CrossRef]
- Chopra, D.; Gulati, K.; Ivanovski, S. Understanding and optimizing the antibacterial functions of anodized nano-engineered titanium implants. Acta Biomater. 2021, 127, 80–101. [Google Scholar] [CrossRef]
- Bowen, P.K.; Shearier, E.R.; Zhao, S.; Guillory, R.J., 2nd; Zhao, F.; Goldman, J.; Drelich, J.W. Biodegradable Metals for Cardiovascular Stents: From Clinical Concerns to Recent Zn-Alloys. Adv. Healthc. Mater. 2016, 5, 1121–1140. [Google Scholar] [CrossRef]
- Wiesmann, N.; Tremel, W.; Brieger, J. Zinc oxide nanoparticles for therapeutic purposes in cancer medicine. J. Mater. Chem. B 2020, 8, 4973–4989. [Google Scholar] [CrossRef] [PubMed]
- Jiang, S.; Lin, K.; Cai, M. ZnO Nanomaterials: Current Advancements in Antibacterial Mechanisms and Applications. Front. Chem. 2020, 8, 580. [Google Scholar] [CrossRef] [PubMed]
- Jiang, Y.; Xiong, Z.; Huang, J.; Yan, F.; Yao, G.; Lai, B. Effective E. coli inactivation of core-shell ZnO@ ZIF-8 photocatalysis under visible light synergize with peroxymonosulfate: Efficiency and mechanism. Chin. Chem. Letters 2022, 33, 415–423. [Google Scholar] [CrossRef]
- Mahamuni-Badiger, P.P.; Patil, P.M.; Badiger, M.V.; Patel, P.R.; Gadgil, B.S.T.; Pandit, A.; Bohara, R.A. Biofilm formation to inhibition: Role of zinc oxide-based nanoparticles. Mater. Sci. Eng. C 2020, 108, 110319. [Google Scholar] [CrossRef]
- Sanati, S.; Abazari, R.; Morsali, A.; Kirillov, A.M.; Junk, P.C.; Wang, J. An Asymmetric Supercapacitor Based on a Non-Calcined 3D Pillared Cobalt(II) Metal–Organic Framework with Long Cyclic Stability. Inorg. Chem. 2019, 58, 16100–16111. [Google Scholar] [CrossRef]
- Bai, S.; Liu, C.; Luo, R.; Chen, A. Metal organic frameworks-derived sensing material of SnO2/NiO composites for detection of triethylamine. Appl. Surf. Sci. 2018, 437, 304–313. [Google Scholar] [CrossRef]
- Chen, B.; Yang, X.; Zeng, X.; Huang, Z.; Xiao, J.; Wang, J.; Zhan, G. Multicomponent metal oxides derived from Mn-BTC anchoring with metal acetylacetonate complexes as excellent catalysts for VOCs and CO oxidation. Chem. Eng. J. 2020, 397, 125424. [Google Scholar] [CrossRef]
- Guo, S.; Zhao, Y.; Yuan, H.; Wang, C.; Jiang, H.; Cheng, G.J. Ultrafast Laser Manufacture of Stable, Efficient Ultrafine Noble Metal Catalysts Mediated with MOF Derived High Density Defective Metal Oxides. Small 2020, 16, e2000749. [Google Scholar] [CrossRef]
- Liu, Y.; Cheng, H.; Cheng, M.; Liu, Z.; Huang, D.; Zhang, G.; Shao, B.; Liang, Q.; Luo, S.; Wu, T.; et al. The application of Zeolitic imidazolate frameworks (ZIFs) and their derivatives based materials for photocatalytic hydrogen evolution and pollutants treatment. Chem. Eng. J. 2021, 417, 127914. [Google Scholar] [CrossRef]
- Salunkhe, R.R.; Kaneti, Y.V.; Yamauchi, Y. Metal–Organic Framework-Derived Nanoporous Metal Oxides toward Supercapacitor Applications: Progress and Prospects. ACS Nano 2017, 11, 5293–5308. [Google Scholar] [CrossRef] [PubMed]
- Li, Y.; Zhang, J.; Chen, Q.; Xia, X.; Chen, M. Emerging of Heterostructure Materials in Energy Storage: A Review. Adv. Mater. 2021, 33, e2100855. [Google Scholar] [CrossRef] [PubMed]
- Kang, W.; Wang, Y.; Wan, Y.; Tuo, Y.; Wang, X.; Sun, D. Embedding anion-doped Fe7S8 in N-doped carbon matrix and shell for fast and stable sodium storage. Mater. Chem. Phys. 2021, 264, 124456. [Google Scholar] [CrossRef]
- Xia, Y.; Fan, X.; Yang, H.; Li, L.; He, C.; Cheng, C.; Haag, R. ZnO/Nanocarbons-Modified Fibrous Scaffolds for Stem Cell-Based Osteogenic Differentiation. Small 2020, 16, 2003010. [Google Scholar] [CrossRef] [PubMed]
- Johnston, H.J.; Hutchison, G.R.; Christensen, F.M.; Peters, S.; Hankin, S.; Aschberger, K.; Stone, V. A critical review of the biological mechanisms underlying the in vivo and in vitro toxicity of carbon nanotubes: The contribution of physicochemical characteristics. Nanotoxicology 2010, 4, 207–246. [Google Scholar] [CrossRef]
- Qi, K.; Cheng, B.; Yu, J.; Ho, W. Review on the improvement of the photocatalytic and antibacterial activities of ZnO. J. Alloys Compd. 2017, 727, 792–820. [Google Scholar] [CrossRef]
- Ravichandiran, P.; Masłyk, M.; Sheet, S.; Janeczko, M.; Premnath, D.; Kim, A.R.; Park, B.H.; Han, M.K.; Yoo, D.J. Synthesis and antimicrobial evaluation of 1, 4-naphthoquinone derivatives as potential antibacterial agents. ChemistryOpen 2019, 8, 589–600. [Google Scholar] [CrossRef]
- Subramaniyan, S.A.; Sheet, S.; Vinothkannan, M.; Yoo, D.J.; Lee, Y.S.; Belal, S.A.; Shim, K.S. One-pot facile synthesis of Pt nanoparticles using cultural filtrate of microgravity simulated grown P. chrysogenum and their activity on bacteria and cancer cells. J. Nanosci. Nanotechnol. 2018, 18, 3110–3125. [Google Scholar] [CrossRef]
- Shuai, C.; Yang, W.; Feng, P.; Peng, S.; Pan, H. Accelerated degradation of HAP/PLLA bone scaffold by PGA blending facilitates bioactivity and osteoconductivity. Bioact. Mater. 2021, 6, 490–502. [Google Scholar] [CrossRef]
- Ji, H.; Zhao, M.-C.; Xie, B.; Zhao, Y.-C.; Yin, D.; Gao, C.; Shuai, C.; Atrens, A. Corrosion and antibacterial performance of novel selective-laser-melted (SLMed) Ti-xCu biomedical alloys. J. Alloys Compd. 2021, 864, 158415. [Google Scholar] [CrossRef]
- Yang, R.; Yan, X.; Li, Y.; Zhang, X.; Chen, J. Nitrogen-doped porous carbon-ZnO nanopolyhedra derived from ZIF-8: New materials for photoelectrochemical biosensors. ACS Appl. Mater. Interfaces 2017, 9, 42482–42491. [Google Scholar] [CrossRef] [PubMed]
- Lv, R.; Zhang, Q.; Wang, W.; Lin, Y.; Zhang, S. ZnO@ ZIF-8 Core-Shell Structure Gas Sensors with Excellent Selectivity to H2. Sensors 2021, 21, 4069. [Google Scholar] [CrossRef] [PubMed]
- Duarah, R.; Karak, N. Hyperbranched polyurethane/reduced carbon dot-zinc oxide nanocomposite-mediated solar-assisted photocatalytic degradation of organic contaminant: An approach towards environmental remediation. Chem. Eng. J. 2019, 370, 716–728. [Google Scholar] [CrossRef]
- Samuel, E.; Joshi, B.; Kim, M.-W.; Kim, Y.-I.; Swihart, M.T.; Yoon, S.S. Hierarchical zeolitic imidazolate framework-derived manganese-doped zinc oxide decorated carbon nanofiber electrodes for high performance flexible supercapacitors. Chem. Eng. J. 2019, 371, 657–665. [Google Scholar] [CrossRef]
- Wang, A.; Ni, J.; Wang, W.; Wang, X.; Liu, D.; Zhu, Q. MOF-derived N-doped ZnO carbon skeleton@ hierarchical Bi2MoO6 S-scheme heterojunction for photodegradation of SMX: Mechanism, pathways and DFT calculation. J. Hazard. Mater. 2022, 426, 128106. [Google Scholar] [CrossRef] [PubMed]
- Tabassum, H.; Qu, C.; Cai, K.; Aftab, W.; Liang, Z.; Qiu, T.; Mahmood, A.; Meng, W.; Zou, R. Large-scale fabrication of BCN nanotube architecture entangled on a three-dimensional carbon skeleton for energy storage. J. Mater. Chem. A 2018, 6, 21225–21230. [Google Scholar] [CrossRef]
- Fan, C.; Tang, Y.; Wang, H.; Huang, Y.; Xu, F.; Yang, Y.; Huang, Y.; Rong, W.; Lin, Y. ZIF-90 with biomimetic Zn–N coordination structures as an effective nanozyme to mimic natural hydrolase. Nanoscale 2022, 14, 7985–7990. [Google Scholar] [CrossRef]
- Wahab, R.; Hwang, I.; Kim, Y.-S.; Shin, H.-S. Photocatalytic activity of zinc oxide micro-flowers synthesized via solution method. Chem. Eng. J. 2011, 168, 359–366. [Google Scholar] [CrossRef]
- Panigrahy, B.; Aslam, M.; Bahadur, D. Aqueous Synthesis of Mn- and Co-Doped ZnO Nanorods. J. Phys. Chem. C 2010, 114, 11758–11763. [Google Scholar] [CrossRef]
- Liu, X.; Wang, L.-S.; Ma, Y.; Zheng, H.; Lin, L.; Zhang, Q.; Chen, Y.; Qiu, Y.; Peng, D.-L. Enhanced microwave absorption properties by tuning cation deficiency of perovskite oxides of two-dimensional LaFeO3/C composite in X-band. ACS Appl. Mater. Interfaces 2017, 9, 7601–7610. [Google Scholar] [CrossRef]
- Abdalkarim, S.Y.H.; Yu, H.-Y.; Song, M.-L.; Zhou, Y.; Yao, J.; Ni, Q.-Q. In vitro degradation and possible hydrolytic mechanism of PHBV nanocomposites by incorporating cellulose nanocrystal-ZnO nanohybrids. Carbohydr. Polym. 2017, 176, 38–49. [Google Scholar] [CrossRef] [PubMed]
- Wang, R.; He, X.; Gao, Y.; Zhang, X.; Yao, X.; Tang, B. Antimicrobial property, cytocompatibility and corrosion resistance of Zn-doped ZrO2/TiO2 coatings on Ti6Al4V implants. Mater. Sci. Eng. C 2017, 75, 7–15. [Google Scholar] [CrossRef] [PubMed]
- Qian, G.; Zhang, L.; Wang, G.; Zhao, Z.; Peng, S.; Shuai, C. 3D Printed Zn-doped Mesoporous Silica-incorporated Poly-L-lactic Acid Scaffolds for Bone Repair. Int. J. Bioprint. 2021, 7, 346. [Google Scholar] [CrossRef] [PubMed]
- Lu, X.; Sun, Y.; Han, M.; Chen, D.; Wang, A.; Sun, K. Silk fibroin double-layer microneedles for the encapsulation and controlled release of triptorelin. Int. J. Pharm. 2022, 613, 121433. [Google Scholar] [CrossRef]
- Ye, S.; Jiang, L.; Su, C.; Zhu, Z.; Wen, Y.; Shao, W. Development of gelatin/bacterial cellulose composite sponges as potential natural wound dressings. Int. J. Biol. Macromol. 2019, 133, 148–155. [Google Scholar] [CrossRef] [PubMed]
- Thein-Han, W.; Saikhun, J.; Pholpramoo, C.; Misra, R.; Kitiyanant, Y. Chitosan–gelatin scaffolds for tissue engineering: Physico-chemical properties and biological response of buffalo embryonic stem cells and transfectant of GFP–buffalo embryonic stem cells. Acta Biomater. 2009, 5, 3453–3466. [Google Scholar] [CrossRef]

Disclaimer/Publisher’s Note: The statements, opinions and data contained in all publications are solely those of the individual author(s) and contributor(s) and not of MDPI and/or the editor(s). MDPI and/or the editor(s) disclaim responsibility for any injury to people or property resulting from any ideas, methods, instructions or products referred to in the content. |
© 2023 by the authors. Licensee MDPI, Basel, Switzerland. This article is an open access article distributed under the terms and conditions of the Creative Commons Attribution (CC BY) license (https://creativecommons.org/licenses/by/4.0/).
Share and Cite
Yuan, X.; Zhu, W.; Yang, Z.; Chen, F.; Han, X. Three-Dimensional Printing of Poly-L-Lactic Acid Composite Scaffolds with Enhanced Bioactivity and Controllable Zn Ion Release Capability by Coupling with Carbon-ZnO. Bioengineering 2023, 10, 307. https://doi.org/10.3390/bioengineering10030307
Yuan X, Zhu W, Yang Z, Chen F, Han X. Three-Dimensional Printing of Poly-L-Lactic Acid Composite Scaffolds with Enhanced Bioactivity and Controllable Zn Ion Release Capability by Coupling with Carbon-ZnO. Bioengineering. 2023; 10(3):307. https://doi.org/10.3390/bioengineering10030307
Chicago/Turabian StyleYuan, Xun, Wei Zhu, Zhongyuan Yang, Feng Chen, and Xiaoxiao Han. 2023. "Three-Dimensional Printing of Poly-L-Lactic Acid Composite Scaffolds with Enhanced Bioactivity and Controllable Zn Ion Release Capability by Coupling with Carbon-ZnO" Bioengineering 10, no. 3: 307. https://doi.org/10.3390/bioengineering10030307
APA StyleYuan, X., Zhu, W., Yang, Z., Chen, F., & Han, X. (2023). Three-Dimensional Printing of Poly-L-Lactic Acid Composite Scaffolds with Enhanced Bioactivity and Controllable Zn Ion Release Capability by Coupling with Carbon-ZnO. Bioengineering, 10(3), 307. https://doi.org/10.3390/bioengineering10030307
